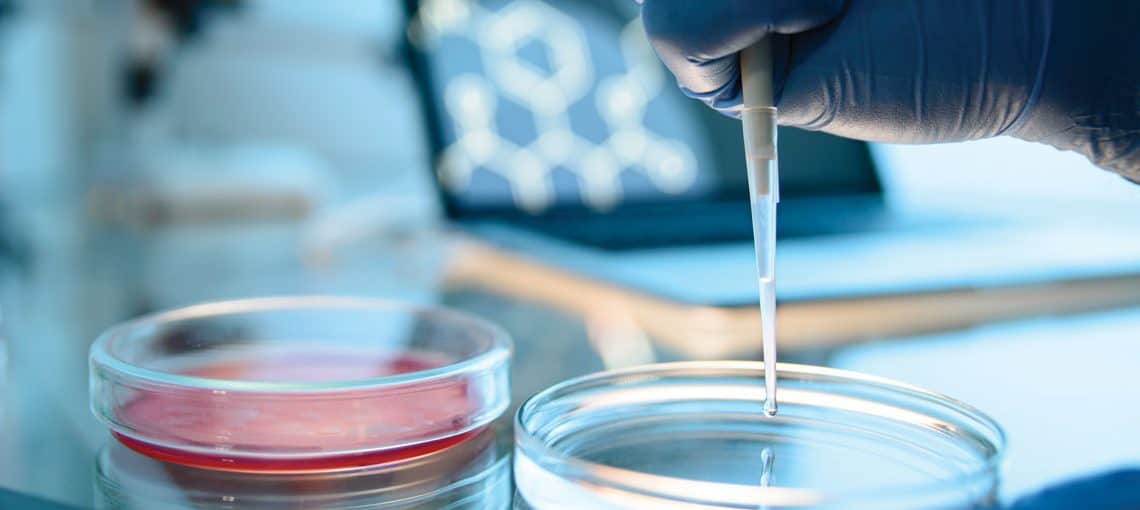
5 Ways Your Donation Helps Rural Albertans Facing Cancer 2 Embracing AI Community image

How the Patient Financial Assistance Program Provides Relief
Financial strain for cancer patients in active treatment can be a heavy burden. This donor-funded relief program seeks to cover some of those costs

Financial strain for cancer patients in active treatment can be a heavy burden. This donor-funded relief program seeks to cover some of those costs
One third of Alberta’s cancer patients receive care in centres outside of Calgary and Edmonton

The Mickleborough Interfacial Bioscience Research Program has embraced a collaborative approach for funding medical research

It’s a big operation to ensure that every rider in the Enbridge Ride to Conquer Cancer pedals triumphantly past the finish line

Cancer mortality rates in Alberta have been falling on average by 2.1 percent each year since 2004

It’s one of the biggest philanthropy events on campus and has been going on for 15 years

An unanticipated surprise for the 10th anniversary of the largest cycling fundraiser in Alberta didn’t stop it from raising $8.12 million

This fall, Len Rhodes dedicated a home game to cancer research and care

Allison Wusaty set her sights on Europe’s highest peak to raise funds in support of her brother

They want to help ensure that all Albertans facing cancer have access to the best and most advanced options for treatment and support